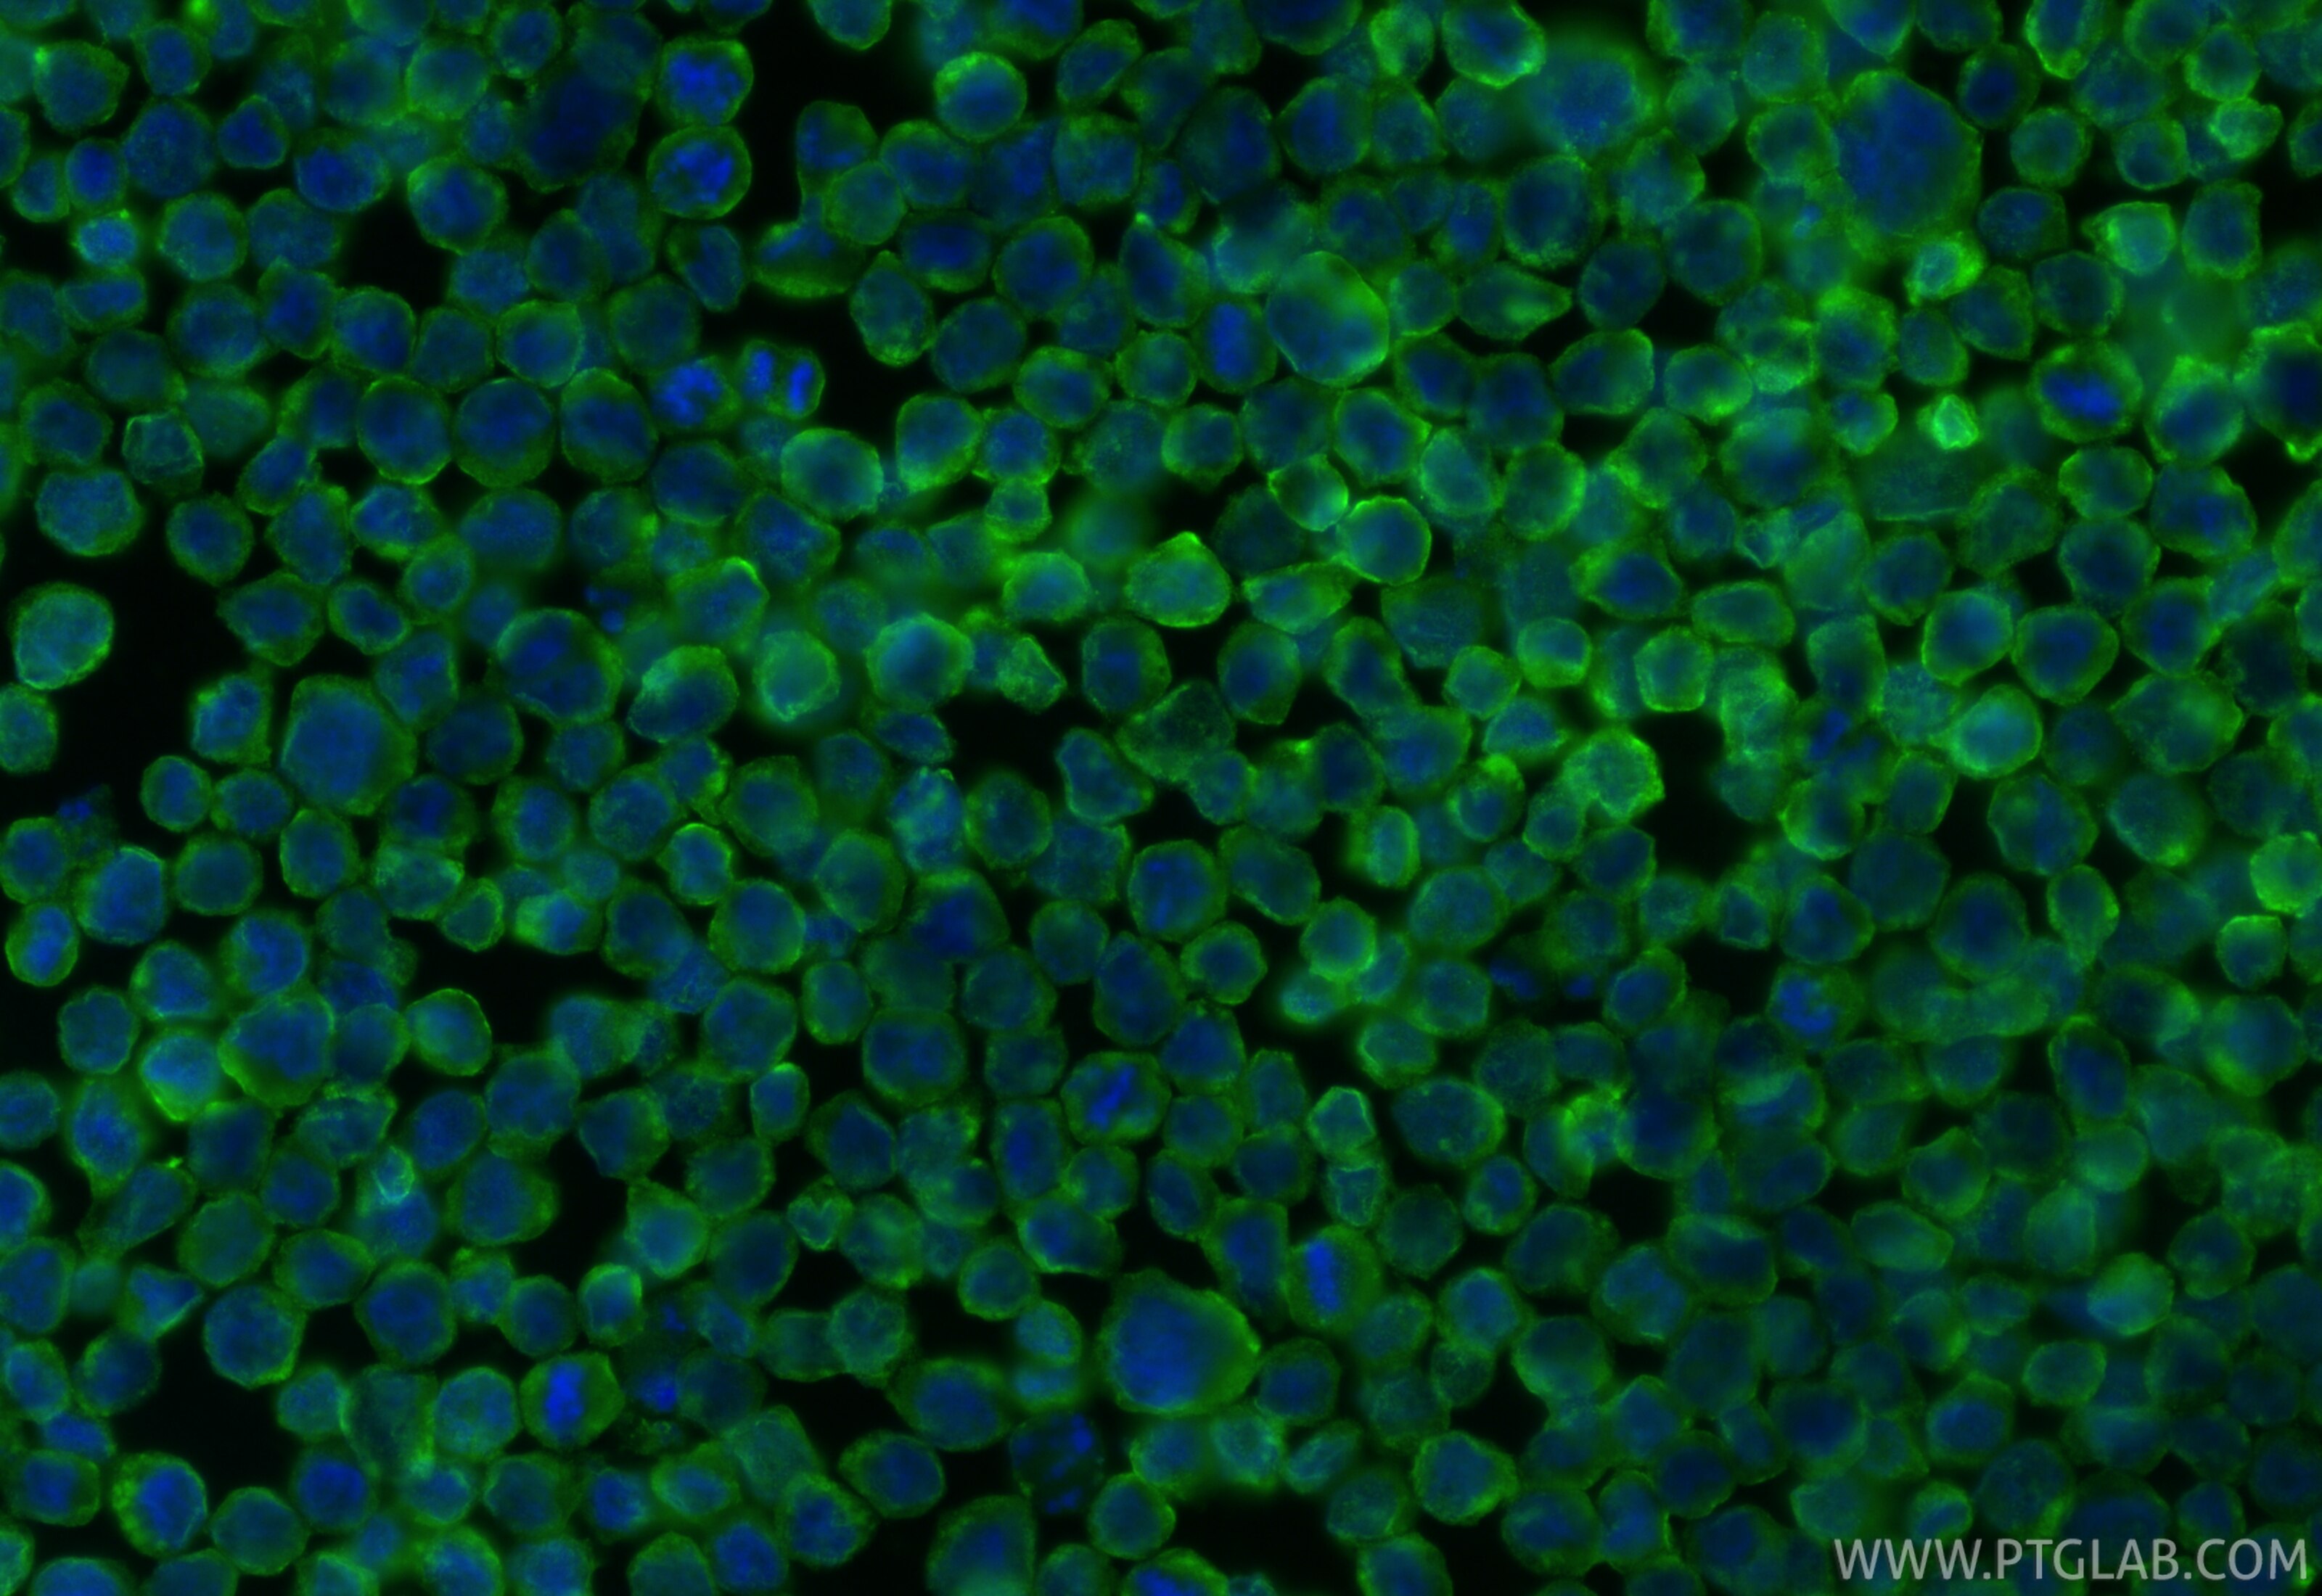
Immunofluorescence (IF) / fluorescent staining of HL-60 cells using IL-27RA Polyclonal antibody (12308-1-AP)

Tested Applications
| Positive WB detected in | HL-60 cells, K-562 cells, TF-1 cells |
| Positive IF/ICC detected in | HL-60 cells |
Recommended dilution
| Application | Dilution |
|---|---|
| Western Blot (WB) | WB : 1:1000-1:4000 |
| Immunofluorescence (IF)/ICC | IF/ICC : 1:200-1:800 |
| It is recommended that this reagent should be titrated in each testing system to obtain optimal results. | |
| Sample-dependent, Check data in validation data gallery. | |
Published Applications
| WB | See 1 publications below |
Product Information
12308-1-AP targets IL-27RA in WB, IF/ICC, ELISA applications and shows reactivity with human samples.
| Tested Reactivity | human |
| Cited Reactivity | mouse |
| Host / Isotype | Rabbit / IgG |
| Class | Polyclonal |
| Type | Antibody |
| Immunogen |
CatNo: Ag2956 Product name: Recombinant human IL-27RA protein Source: e coli.-derived, PGEX-4T Tag: GST Domain: 33-515 aa of BC028003 Sequence: QGSAGPLQCYGVGPLGDLNCSWEPLGDLGAPSELHLQSQKYRSNKTQTVAVAAGRSWVAIPREQLTMSDKLLVWGTKAGQPLWPPVFVNLETQMKPNAPRLGPDVDFSEDDPLEATVHWAPPTWPSHKVLICQFHYRRCQEAAWTLLEPELKTIPLTPVEIQDLELATGYKVYGRCRMEKEEDLWGEWSPILSFQTPPSAPKDVWVSGNLCGTPGGEEPLLLWKAPGPCVQVSYKVWFWVGGRELSPEGITCCCSLIPSGAEWARVSAVNATSWEPLTNLSLVCLDSASAPRSVAVSSIAGSTELLVTWQPGPGEPLEHVVDWARDGDPLEKLNWVRLPPGNLSALLPGNFTVGVPYRITVTAVSASGLASASSVWGFREELAPLVGPTLWRLQDAPPGTPAIAWGEVPRHQLRGHLTHYTLCAQSGTSPSVCMNVSGNTQSVTLPDLPWGPCELWVTASTIAGQGPPGPILRLHLPDNTLRW Predict reactive species |
| Full Name | interleukin 27 receptor, alpha |
| Calculated Molecular Weight | 636 aa, 69 kDa |
| Observed Molecular Weight | 70 kDa |
| GenBank Accession Number | BC028003 |
| Gene Symbol | IL27RA |
| Gene ID (NCBI) | 9466 |
| RRID | AB_3669136 |
| Conjugate | Unconjugated |
| Form | Liquid |
| Purification Method | Antigen affinity purification |
| UNIPROT ID | Q6UWB1 |
| Storage Buffer | PBS with 0.02% sodium azide and 50% glycerol, pH 7.3. |
| Storage Conditions | Store at -20°C. Stable for one year after shipment. Aliquoting is unnecessary for -20oC storage. 20ul sizes contain 0.1% BSA. |
Background Information
IL-27RA, also known as T-cell cytokine receptor WSX-1 or TCCR, is a unique receptor subunit for the cytokine IL-27. It is expressed in a variety of cells including activated T cells, NK cells, mast cells, endothelial cells, activated B cells, monocytes, Langerhans cells, and activated dendritic cells (PMID: 18378322). The interaction with IL-27 leads to the phosphorylation of Jak and STAT proteins, which are crucial for the regulation of immune responses (PMID: 28536468). IL-27RA plays a significant role in immune cell activation and differentiation, particularly in the context of Th1 and Th17 cells (PMID: 38566992).
Protocols
| Product Specific Protocols | |
|---|---|
| IF protocol for IL-27RA antibody 12308-1-AP | Download protocol |
| WB protocol for IL-27RA antibody 12308-1-AP | Download protocol |
| Standard Protocols | |
|---|---|
| Click here to view our Standard Protocols |